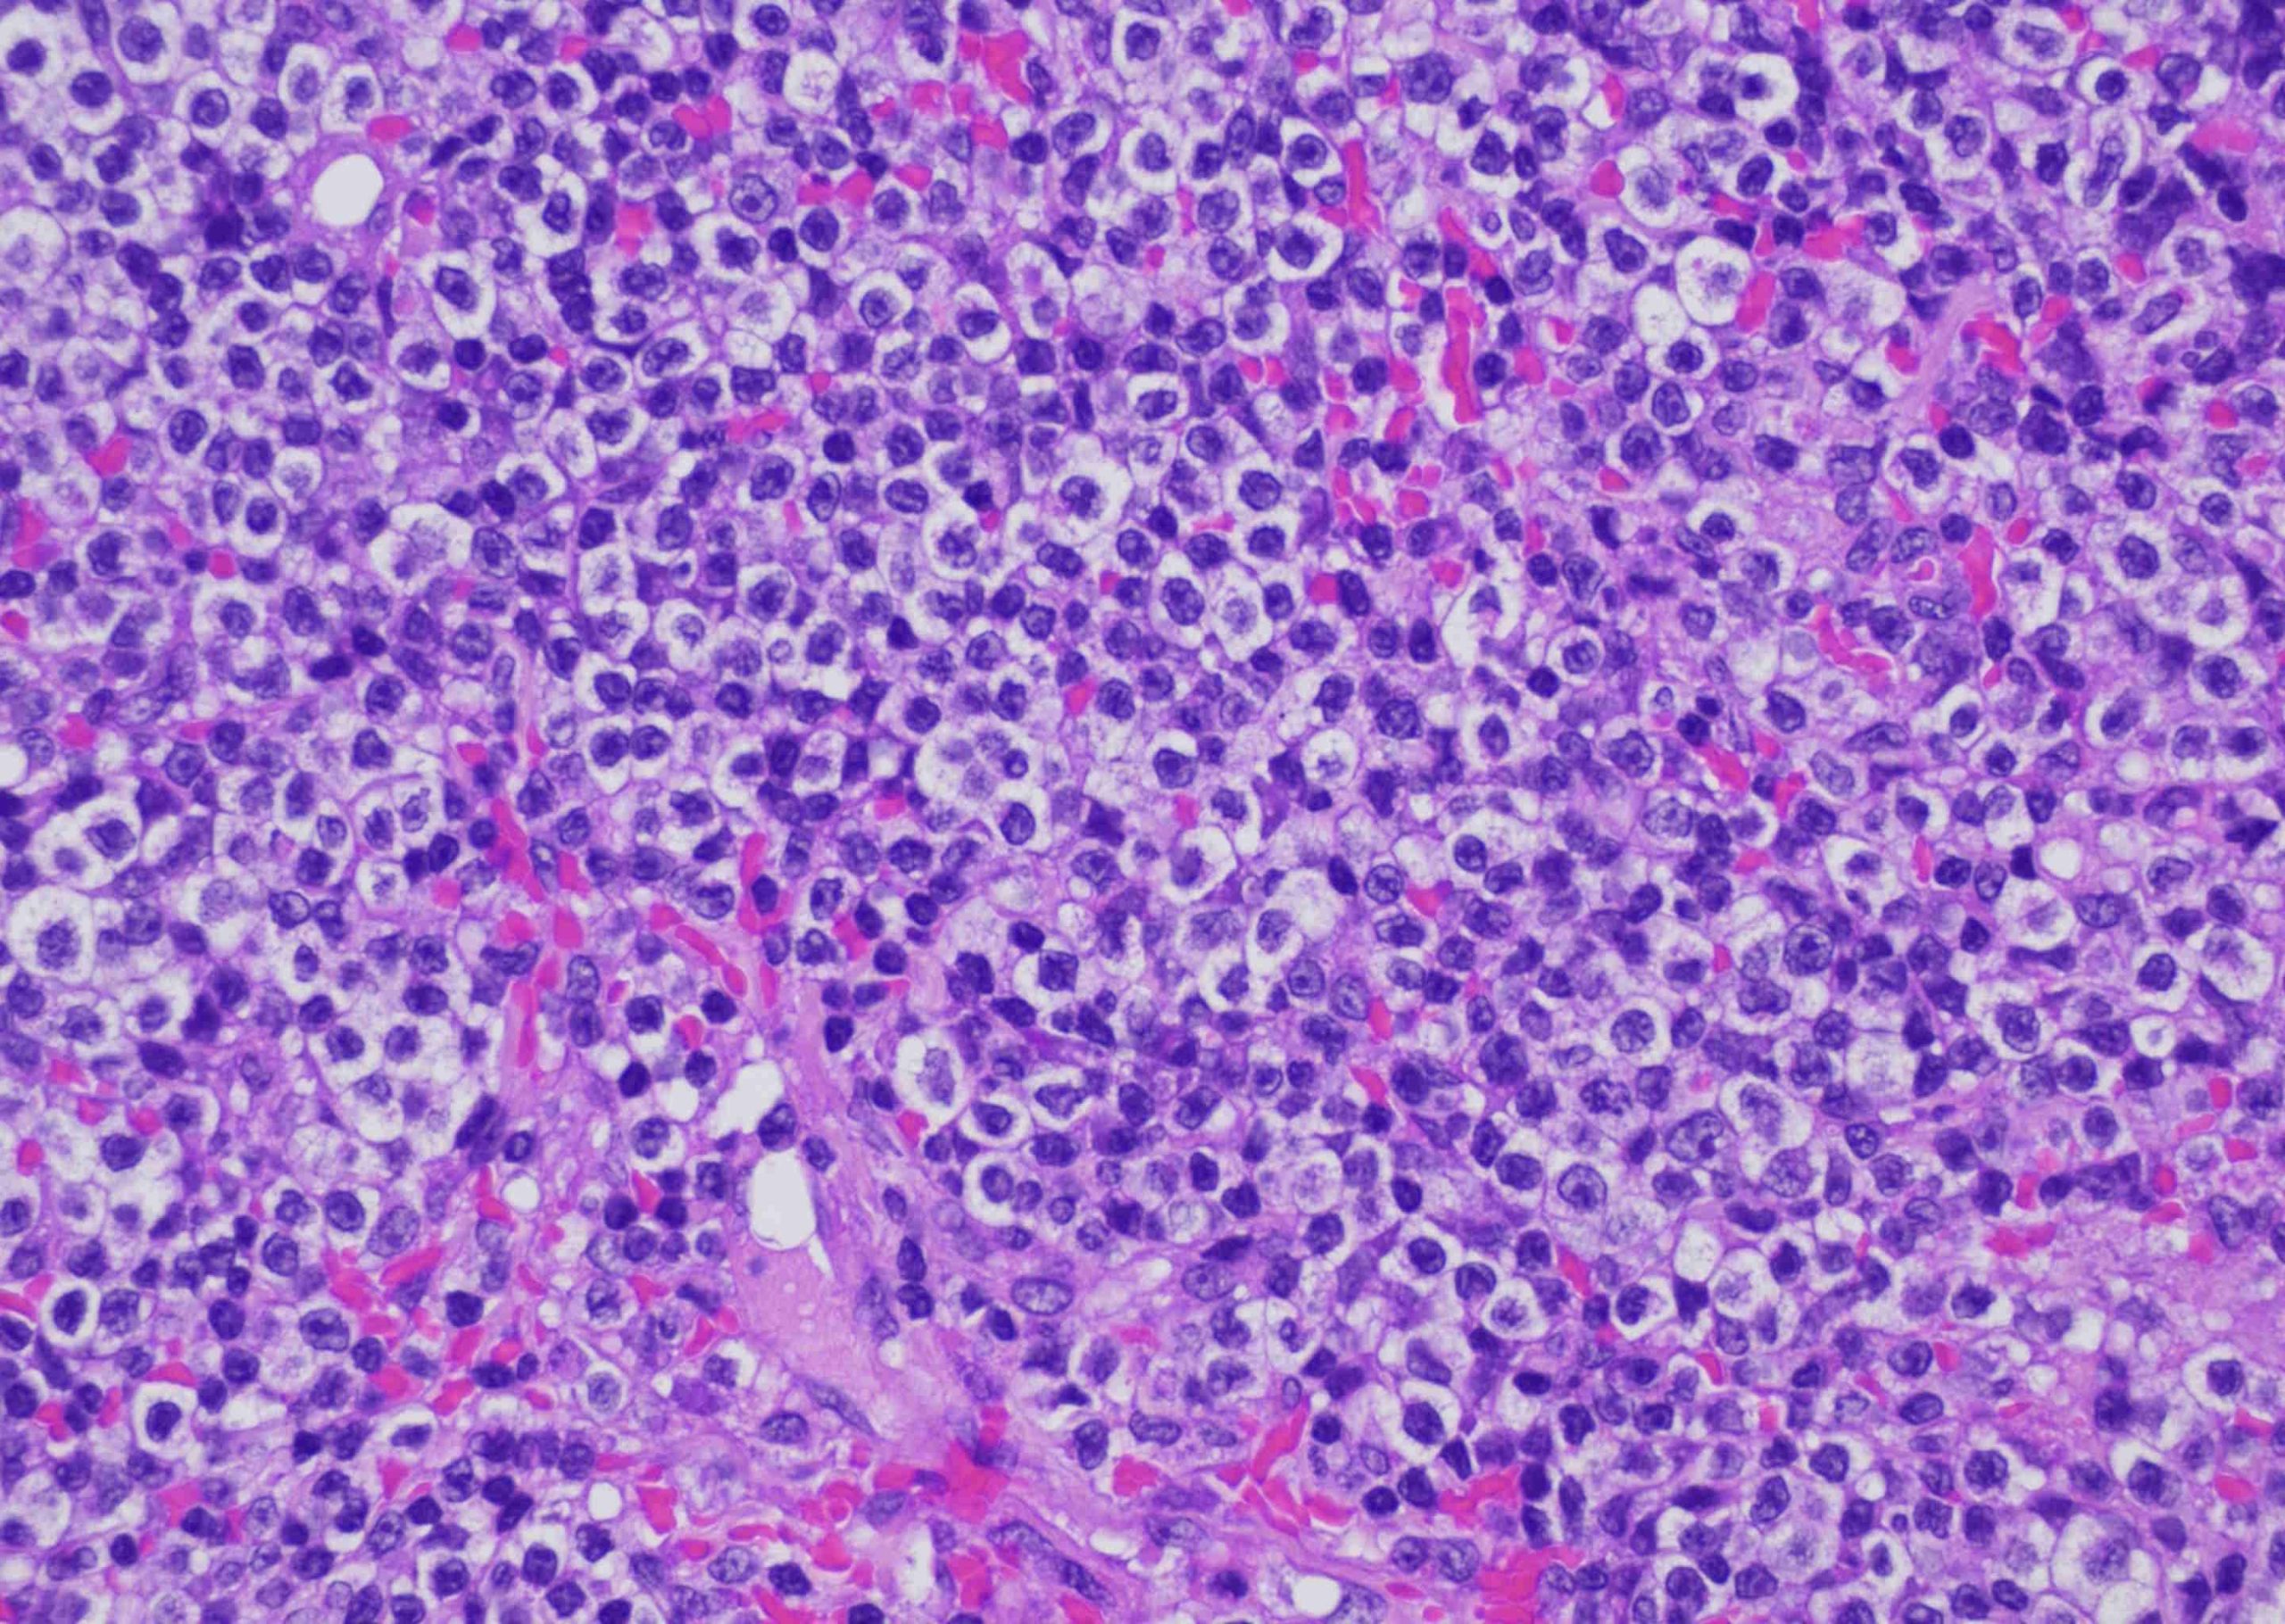

(腫瘍の症例:16)上皮向性リンパ腫に負けなかった子
ワンちゃん ビーグル 去勢雄 初発時16歳3か月
病歴:
昔からマラセチアや細菌性の外耳炎や毛包上皮腫・軟性線維種等の腫瘍、歯肉過形成や膀胱の炎症性ポリープ、指間炎がありましたが、13歳には肝臓癌を発症して翌年の再手術を含め二度の手術をしている子です。その都度でするべき検査や処置をちゃんとしてくれるので平均寿命を超えて無事に16歳を迎えました。
症状:
急に黒い鼻(鼻鏡)が白っぽくなってきました。老化して退色する事は特定の日本犬などで有ります。また擦ってめくれた後に色が落ちて傷跡として残る事もあります(ウチの猫さんがそうです・・・ケージから脱出しようとして鼻で擦り過ぎて色が落ちちゃいました)。
ただ・・・ちょっと部分的で気になりました。でもそれをハッキリさせるには皮膚生検が必要で、そうなると全身麻酔です。大きな肝臓の手術を二度して16歳を超えた子に対しては慎重にならざるを得ません。
様子見をして3週位、鼻の脱色部は白からピンクそして赤になっています。つまり炎症を起こしている事が想定されます。もちろん単純に鼻炎からの炎症だってあるのですが、痂疲(カサブタ)を伴っていたり「何か変だな?」と感じる勘が働きました。

口腔内も従来の歯周病とは違う変な赤さが時にはびらん(めくれる事)を伴って口唇にまで認められます。

口の中は詳しくは見せてくれないのですが、ヨダレも多く、食事の際に痛そうしています。食べられないのは困ります。
色々な鑑別が考えられるのですが(怪しむ病気が有っても、いきなり決めつける事はできません)、



表面上の検査や試験的な投薬では難しいと判断しました。確定には鼻鏡と口腔粘膜の精査をさせて頂くしかありません。もちろん高齢ですし要相談なのですが、今までの熱心さを考えるとご決断を頂けると信じて提案をしました。食べられなくなって体力が落ちるまでの決断が大切です。
麻酔を掛けて口腔内を見ると可哀想にびらんや潰瘍があり、痛そうで可哀想でした。これは食べたく無いでしょう。
 鼻の部位の生検は非常に出血しますので、麻酔が必要ですしコツが必要です。
鼻の部位の生検は非常に出血しますので、麻酔が必要ですしコツが必要です。
 口唇は歯肉炎もあるので慎重に場所を選びます。
口唇は歯肉炎もあるので慎重に場所を選びます。
 凄い数のリンパ球が出現しています・・・。
凄い数のリンパ球が出現しています・・・。
ただの炎症だと良かったのですが、予想通り「上皮向性リンパ腫」でした。これは表皮に限定して増殖するリンパ腫です。そうすると命には影響が少なそうなのですが、大多数のヒトの上皮向性リンパ腫と違って、犬は非常に予後が悪いです。これはヒトでは非常に悪性なグループに分類されるタイプが犬の主流のタイプだからです。
通常老齢のイヌが多く罹患します。更にやっかいなのは病期により非常に多様な症状を見せる事です。なので本当に単なる皮膚炎にしか見えない場合もあります。全身のかゆみを伴う紅斑および落屑が目立つタイプもありますし

単発あるいは多発の局面や結節の形成をするものもあります。
腫瘍の症例③:ゆう動物病院|京都市の皮膚科認定医 アトピー・難治の皮膚病対応
(参考)非上皮向性リンパ腫も同じ感じになります。➡腫瘍の症例⑥

そして、この子の様に粘膜皮膚の紅斑、浸潤、色素脱、潰瘍浸潤性を起こす場合もあります。特に色素が抜けるのは大切な特徴です。皮膚炎であれば普通は炎症が起きると色素沈着が続発する方が多いです。
要するに「歳を取って急に上記の様な皮膚症状を起こした全てで皮膚リンパ腫を鑑別に入れて考える」事が大切です。
残念ですがイヌの上皮向性リンパ腫の予後は良くありません。米国での安楽死例を含めた症例の報告では、皮膚病変を認めた時からの生存期間は5~10ヶ月です(中央生存が3~5か月の報告もあります)。治療方法はステロイドを土台にロムスチン(輸入薬)・ニムスチン(現在入手困難)・レチノイド(女性への催奇形性)・一般のリンパ腫に準ずる多剤併用化学療法等がありますが、何をしても反応が乏しい事も多く、完治が難しいです(しかし、イヌによっては診断後2年以上も生存する場合もあります)。
粘膜病変がある方が生存期間が長い話もあり、積極的な治療で場合によっては長生きの可能性はありますので、まずは食べられなく元気が無い事からも頑張って治療する事をご提案しました。今までもしっかり治療をして頂いていたので快諾して頂きました。
かと言って超高齢ですので治療で弱らす事も避けたいです。アポキルを大量に投与する方法も報告があるのですが、こんな場合は僕は一択です。ステロイドと共に、ある薬を処方外の頻度で連続投与します。これは通常のリンパ腫でも効果が認められている東大の論文に拠っています。最初は併用したステロイドは漸減し、最終的には4日に一度に減らせました。
10日で口腔・口唇の症状が軽快しました!ご飯も食べられる様になりました。

そして油断せず治療を継続していくと、なんと鼻の色が戻ってきました!初めての経験です。

 正直言って色が戻るとは思ってもみませんでした。
正直言って色が戻るとは思ってもみませんでした。
その後、通院も大変だったと思うのですが毎週の治療の手をゆるめないで継続して頂き、17歳目前で天寿を全うするまで上皮向性リンパ腫の症状に関しては鼻も口も末梢血もリンパ節も完全に抑え続けて天国に旅立ってくれました。
もちろん若い子だと治療の限界がどこかで先に来ていたかも知れませんが、亡くなるまで症状が無く元気に過ごしてくれ、何よりも見た目も戻ってくれた事に、ご家族と一緒に感動しました。病気も年齢も諦めてはダメだな・・・と勉強させて頂きました。